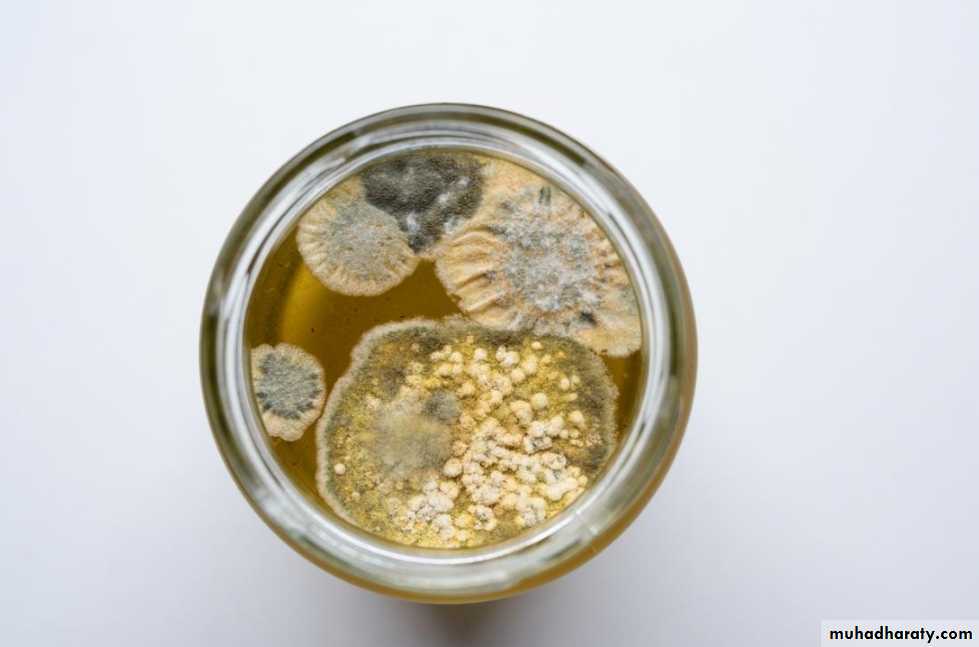
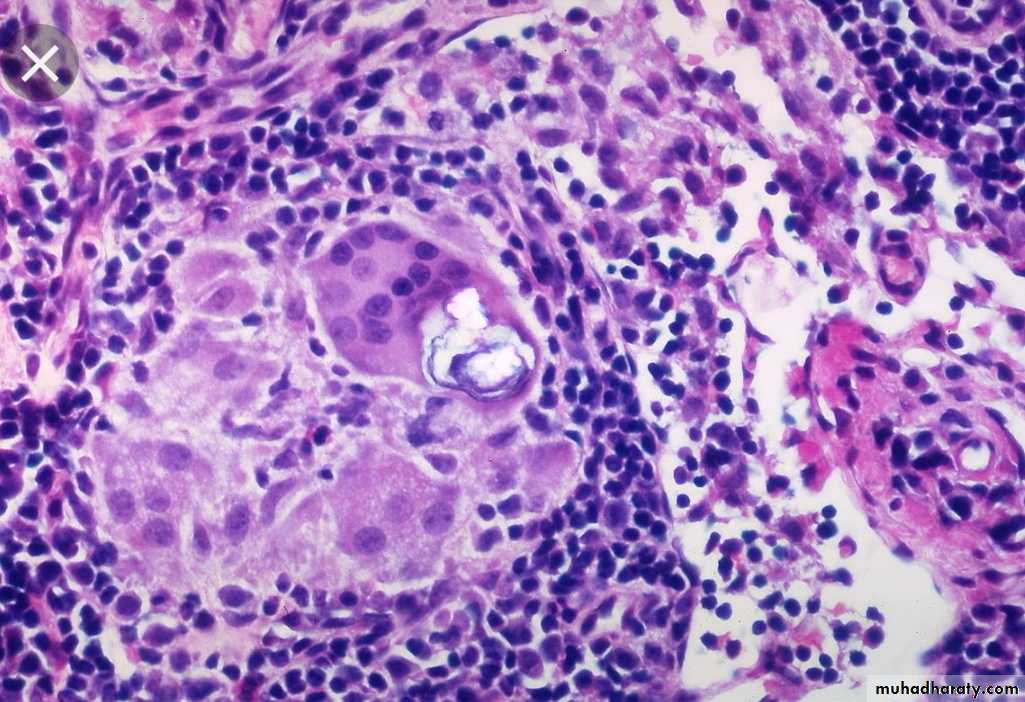

General Pathology of Infectious Diseases
Dr.Zahraa Osama YehyaDepartment of Pathology
Ninevah College of Medicine
Actinomycosis
Caused by Actinomyces israelliiVirtually anaerobic, gram-positive, long filamentous bacteria.
Closely related to mycobacteria with some similarity to fungi.It can be found as a commensal m.o. in the mouth , G.I.T., female genital tract. Only occasionally they invade the tissues it produce infection.
1- Cervicofacial lesion (70%).
2- Abdomial lesion (around iliocecal region or appendix) (15% ).3- Pulmonary lesion (10%).
4- Subcutaneous lesion (5%).
5- Gynecological infection in female with IUCD.
Pathology
Infection produces firm masses containing numerous abscesses ( honeycomb abscesses) bearing colonies as yellowish granules (sulfur granules) with sinuses & fistulae.
Histology
Chronic granulomatous inflammation with suppuration, bacterial colonies, granulation tissue & thick walled capsule & septae.Spirochetes
Are activity motile, Gram negative, unicellular spiral shaped m.o.Produce usually interstitial chronic inflammation with perivascular plasma cell & lymphocytic aggregates.
Syphilis
Caused by spirochete treponema pallidum. It is a chronic venereal disease with multiple clinical presentations.Transmission
It needs close physical sexual contact for transmission.It penetrates the mucosa through a minor or microscopic abrasion.
There is transplacental transmission .Primary syphilis
Lesion (chancre) develops few days or approximately 3 weeks after infection on the glans penis or vulva (90%), anus, lips, fingers & breast in (10%).
Chancre is a solitary, slowly enlarging, hard, painless nodule with superficial ulceration associated with enlarged regional lymph nodes.
* Healing occurs in 3-6 weeks either spontaneously or after treatment.
Microscopically:
UlcerationEndarteritis
Periarteritis ( infiltration by lymphocytes and plasma cells & macrophages )
Spirochetes are numerous at the base of the ulcer
Enlarged lymph node showing reactive hyperplasia& containing spirochetes
Secondary syphilis
Usually develops 1-3 months after infection. It is due to spread & proliferation of the spirochetes within the skin & mucocutaneous tissues.Secondary syphilis occurs in approximately 75%of untreated patients.
* Lesions appear as flat or slightly elevated papules on external genitalia called condylomata lata , generalized macular skin rash, shallow buccal , lingual & pharyngeal ulceration , and generalized lymphadenophathy.Healing may occur spontaneously or after treatment.
Microscopically : same as primary syphilisSome cases progress to tertiary syphilis.
Tertiary syphilisIt appears several years after primary infection (5-30) years
* Tertiary syphilis has 3 main manifestations:
1- CVS syphilis2-CNS neurosyphilis
3-Gumma formation (firm, rubbery, multiple, nodular masses) most commonly found in the liver (heparlobatum) ,bones & testes.
Gumma are now very rare because of the use of the effective antibiotics.
Histology of gummaGranuloma with central coagulative necrosis surrounded by granulation tissue containing numerous chronic inflammatory cells rich in plasma cells with end arteritis obliterans & periarteritis.
The regional L.N. are usually enlarged & may show non- specific acute or chronic lymphadenitis, plasma cells infiltration, or focal epitheliod granuloma.
Congenital syphilis
It is due to transplacental spread, which occurs most frequently during primary & secondary syphilis, when the spirochetes are most numerous.* May cause:
1- Stillbirth, neonatal death or disease present in infancy, childhood or even adult life.2- Desquamating skin rash, particularly of the hands , feet , around the mouth & anus.
3- Osteochondritis (saddle deformity of the nose).
4- Epiphysitis (irregular ossification & bone deformities).
5- Diffuse hepatic fibrosis &interstitial pulmonary fibrosis.
6- Characteristic deformity of the incisor teeth, which is peg-shaped with notched edges (Hutchinson’s teeth) with pitting of the first permanent molars.
7- Later interstitial keratitis produce corneal opacity and eight nerve damage
Diagnosis of syphilis:-
I- History.II- Clinical examination
III- Investigations include two types of serologcal tests:
1) VDRL (venereal disease research laboratory) test.
2) FTA-ABS (Fluorescent treponemal antibody absorption)Test.
Chlamydial infections
Group of spherical m.o. intermediate in size between large viruses & bacteria.
They are an obligate intracellular m.o., proliferate only within host cells, although some may survive extracellularly, they are unable to synthesize ATP at all.Infection spread by a small compact spore-like form (elementary body) which can survive, but not divide, extracellularly.
Chlamydial infections
• In man, they are responsible for the STD lymphogranulomavenerium, which is a small ulcerating primary lesion in the genitalia but with satellite abscesses in the inguinal lymph nodes with extensive scarring & stricture in the anogenital tract.• They cause eye infections, most important is trachoma which is one of the 10 commonest causes of blindness.
Mycoplasmal infections
They are very small filamentous or coccobacillary m.o. which lack cell wall, but classified as a bacteria.They are distributed widely & are pathogenic to many animals & plants.
In man only one species, Mycoplasma pneumoniae, has been shown exclusively to be pathogenic.Mycoplasma pneumonia
It is the cause of one form of atypical (or interstitial) pneumonia which is endemic in most parts of the world especially in childrenMay results in meningo-encephalitis if disseminated in the body with low immunity.
The immune response include the production of a.b. which cross react at low temperature with a human RBC's a.g.& in some cases is responsible for acute hemolysis.
Fungi
These are classified into 3 groups:
Yeasts: round or oval unicellular organisms that replicate by budding or binary fision, some yeast can form chains so called peudohyphae.Moulds: multicellular organisms that grow in form of branching tubules called hyphae, which may be septate or non-septate.
Dimorphic fungi: can grow as yeasts or moulds.
YeastsMOULDS
Candida albicans
The most common fungal infection.It forms yeasts & pseudo-hyphae.
Normal commensal of moist skin, mouth & intestine.
Disease occurs usually after the use of antibiotics because commensal bacteria inhibits candidal proliferation.
Systemic dissemination results in multiple abscesses, occur in immunosuppressed patient.
Oralthrush
ProtozoaToxoplasmosis
Caused by toxoplasma gondiIt can be either acquired or congenital
Acquired Toxoplasmosis
Results from food contaminated by faeces of pets especially cats, or eating of under-cooked meat contaminated by the parasite.Most are asymptomatic.
In symptomatic cases, there is lymphadenitis, especially of cervical l.n., & fever.
In immunosuppressed patient, it can cause encephalitis & hepatitis
Congenital toxoplasmosis
Following transplacental spread from infected, but often asymptomatic, mother.It can cause abortion, stillbirth, cerebral necrosis, hydrocephalus, or blindness.
Sarcoidosis
Chronic granulomatous disease of unknown etiology.
Rare in our locality.Has a chronic coarse with relapse & remision
Affect skin, l.n., bone, lung, etc…Microscopically
non-caseating epitheloid granuloma. The giant cell contain calcified bodies (Schaumanns bodies)Diagnosis
Clinical.Skin test (Kviem test): intradermal injection of sarcoid tissue. In 4 weeks, nodule develops, has a sarcoid appearance.
Biopsy.